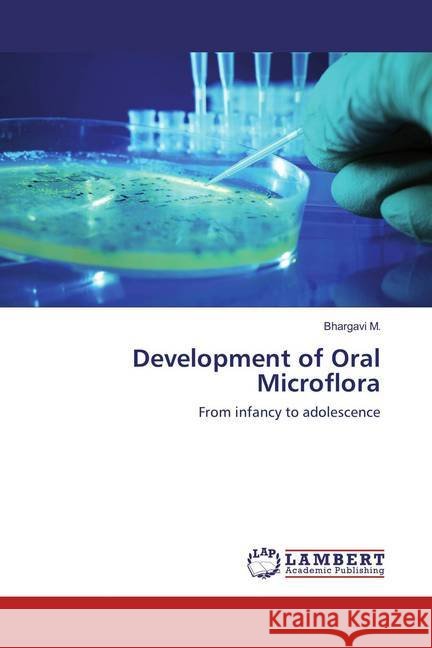
Development of Oral Microflora : From infancy to adolescence M., Bhargavi 9783659863929

Wyniki wyszukiwania:
wyszukanych pozycji: 80
 |
The Golden Parrot and the Magic Teapot
ISBN: 9781482882209 / Angielski / Miękka / 2017 / 28 str. Termin realizacji zamówienia: ok. 16-18 dni roboczych. |
cena:
123,90 |
 |
Ontwikkeling van de orale microflora
ISBN: 9786208524050 / Holenderski / Miękka / 60 str. Termin realizacji zamówienia: ok. 10-14 dni roboczych. |
cena:
179,31 |
 |
Dinosaurs: A Coloring Book with Facts: Awesome Dinosaurs Coloring Book for Kids Age 8 - 15 years
ISBN: 9798860552432 / Angielski / Miękka / 2023 / 90 str. Termin realizacji zamówienia: ok. 16-18 dni roboczych. |
cena:
48,51 |
 |
Saudade
ISBN: 9781685868765 / Angielski / Miękka / 2021 / 272 str. Termin realizacji zamówienia: ok. 16-18 dni roboczych. |
cena:
107,86 |
 |
Secure Storage and Retrieval of Images in Cloud
ISBN: 9786204209364 / Angielski / Miękka / 132 str. Termin realizacji zamówienia: ok. 10-14 dni roboczych. This research has covered three inter-related objectives such as secure transmission of images to public cloud, computationally efficient secure and privacy preserving storage of images in hybrid cloud and content protection mechanism to safeguard interests of the content providers. An extensive review of literature is made to understand present state of the art on computationally efficient, secure and privacy preserving storage and retrieval of images in cloud. The research insights revealed the need for a computationally efficient framework that takes care of secure and privacy preserving...
This research has covered three inter-related objectives such as secure transmission of images to public cloud, computationally efficient secure and p...
|
cena:
278,18 |
 |
Entwicklung der oralen Mikroflora
ISBN: 9786208524067 / Niemiecki / Miękka / 2025 / 64 str. Termin realizacji zamówienia: ok. 16-18 dni roboczych. |
cena:
176,96 |
 |
Desenvolvimento da microflora oral
ISBN: 9786208524104 / Portugalski / Miękka / 2025 / 60 str. Termin realizacji zamówienia: ok. 16-18 dni roboczych. |
cena:
176,96 |
 |
A Practical Handbook of Lean Six Sigma: Continuous Improvement and Operational Excellence Tools
ISBN: 9798344294018 / Angielski / Miękka / 2024 / 352 str. Termin realizacji zamówienia: ok. 16-18 dni roboczych. |
cena:
64,70 |
 |
Sviluppo della microflora orale
ISBN: 9786208524098 / Włoski / Miękka / 2025 / 60 str. Termin realizacji zamówienia: ok. 16-18 dni roboczych. |
cena:
176,96 |
 |
D?veloppement de la microflore buccale
ISBN: 9786208524074 / Francuski / Miękka / 2025 / 64 str. Termin realizacji zamówienia: ok. 16-18 dni roboczych. |
cena:
176,96 |
 |
Charlie and the Corona Pandemic
ISBN: 9798598161036 / Angielski / Miękka / 2021 / 26 str. Termin realizacji zamówienia: ok. 16-18 dni roboczych. |
cena:
40,43 |
 |
Thooral / தூறல்: கவிதையின் தொகுப
ISBN: 9781684873555 / Tamil / Miękka / 2021 / 62 str. Termin realizacji zamówienia: ok. 16-18 dni roboczych. |
cena:
69,02 |
|
Development of Oral Microflora : From infancy to adolescence
ISBN: 9783659863929 / Angielski / Miękka / 2016 / 72 str. Termin realizacji zamówienia: ok. 10-14 dni roboczych. |
cena:
179,31 |
 |
An investigation of hybrid polymer composites
ISBN: 9783659458811 / Angielski / Miękka / 2018 / 120 str. Termin realizacji zamówienia: ok. 10-14 dni roboczych. |
cena:
246,72 |
 |
Production of CGTase from Bacillus subtilis
ISBN: 9786202556095 / Angielski / Miękka / 2020 / 92 str. Termin realizacji zamówienia: ok. 10-14 dni roboczych. |
cena:
246,72 |
 |
Love waits for no tomorrow
ISBN: 9798886298611 / Angielski / Miękka / 2022 / 232 str. Termin realizacji zamówienia: ok. 16-18 dni roboczych. |
cena:
99,23 |
 |
Rate Control Protocol Plus Protocol (RCP+)
ISBN: 9783659954108 / Angielski / Miękka / 2016 / 196 str. Termin realizacji zamówienia: ok. 10-14 dni roboczych. |
cena:
291,66 |
 |
Vague Gamma-Semirings
ISBN: 9786134976947 / Angielski / Miękka / 2018 / 196 str. Termin realizacji zamówienia: ok. 10-14 dni roboczych. |
cena:
291,66 |
 |
Anatomic Evaluation Of Heart Using Echocardiography And Radiography
ISBN: 9786200294371 / Angielski / Miękka / 2019 / 148 str. Termin realizacji zamówienia: ok. 10-14 dni roboczych. |
cena:
278,18 |
 |
L'intelligence artificielle libérée:
ISBN: 9786206339090 / Francuski / Miękka / 68 str. Termin realizacji zamówienia: ok. 10-14 dni roboczych. Les progrès rapides de l'IA ont provoqué une vague d'innovation, ouvrant de nouvelles possibilités et remodelant les paradigmes traditionnels. Des soins de santé à la finance en passant par les transports et l'agriculture, l'IA s'infiltre dans divers secteurs, libérant son potentiel pour résoudre des problèmes complexes, améliorer l'efficacité et enrichir l'expérience humaine.Cet ouvrage vise à explorer les tendances récentes et les applications de l'IA dans des scénarios réels. Il se penche sur les développements de pointe, les percées et les considérations éthiques qui...
Les progrès rapides de l'IA ont provoqué une vague d'innovation, ouvrant de nouvelles possibilités et remodelant les paradigmes traditionnels. Des ...
|
cena:
197,28 |











